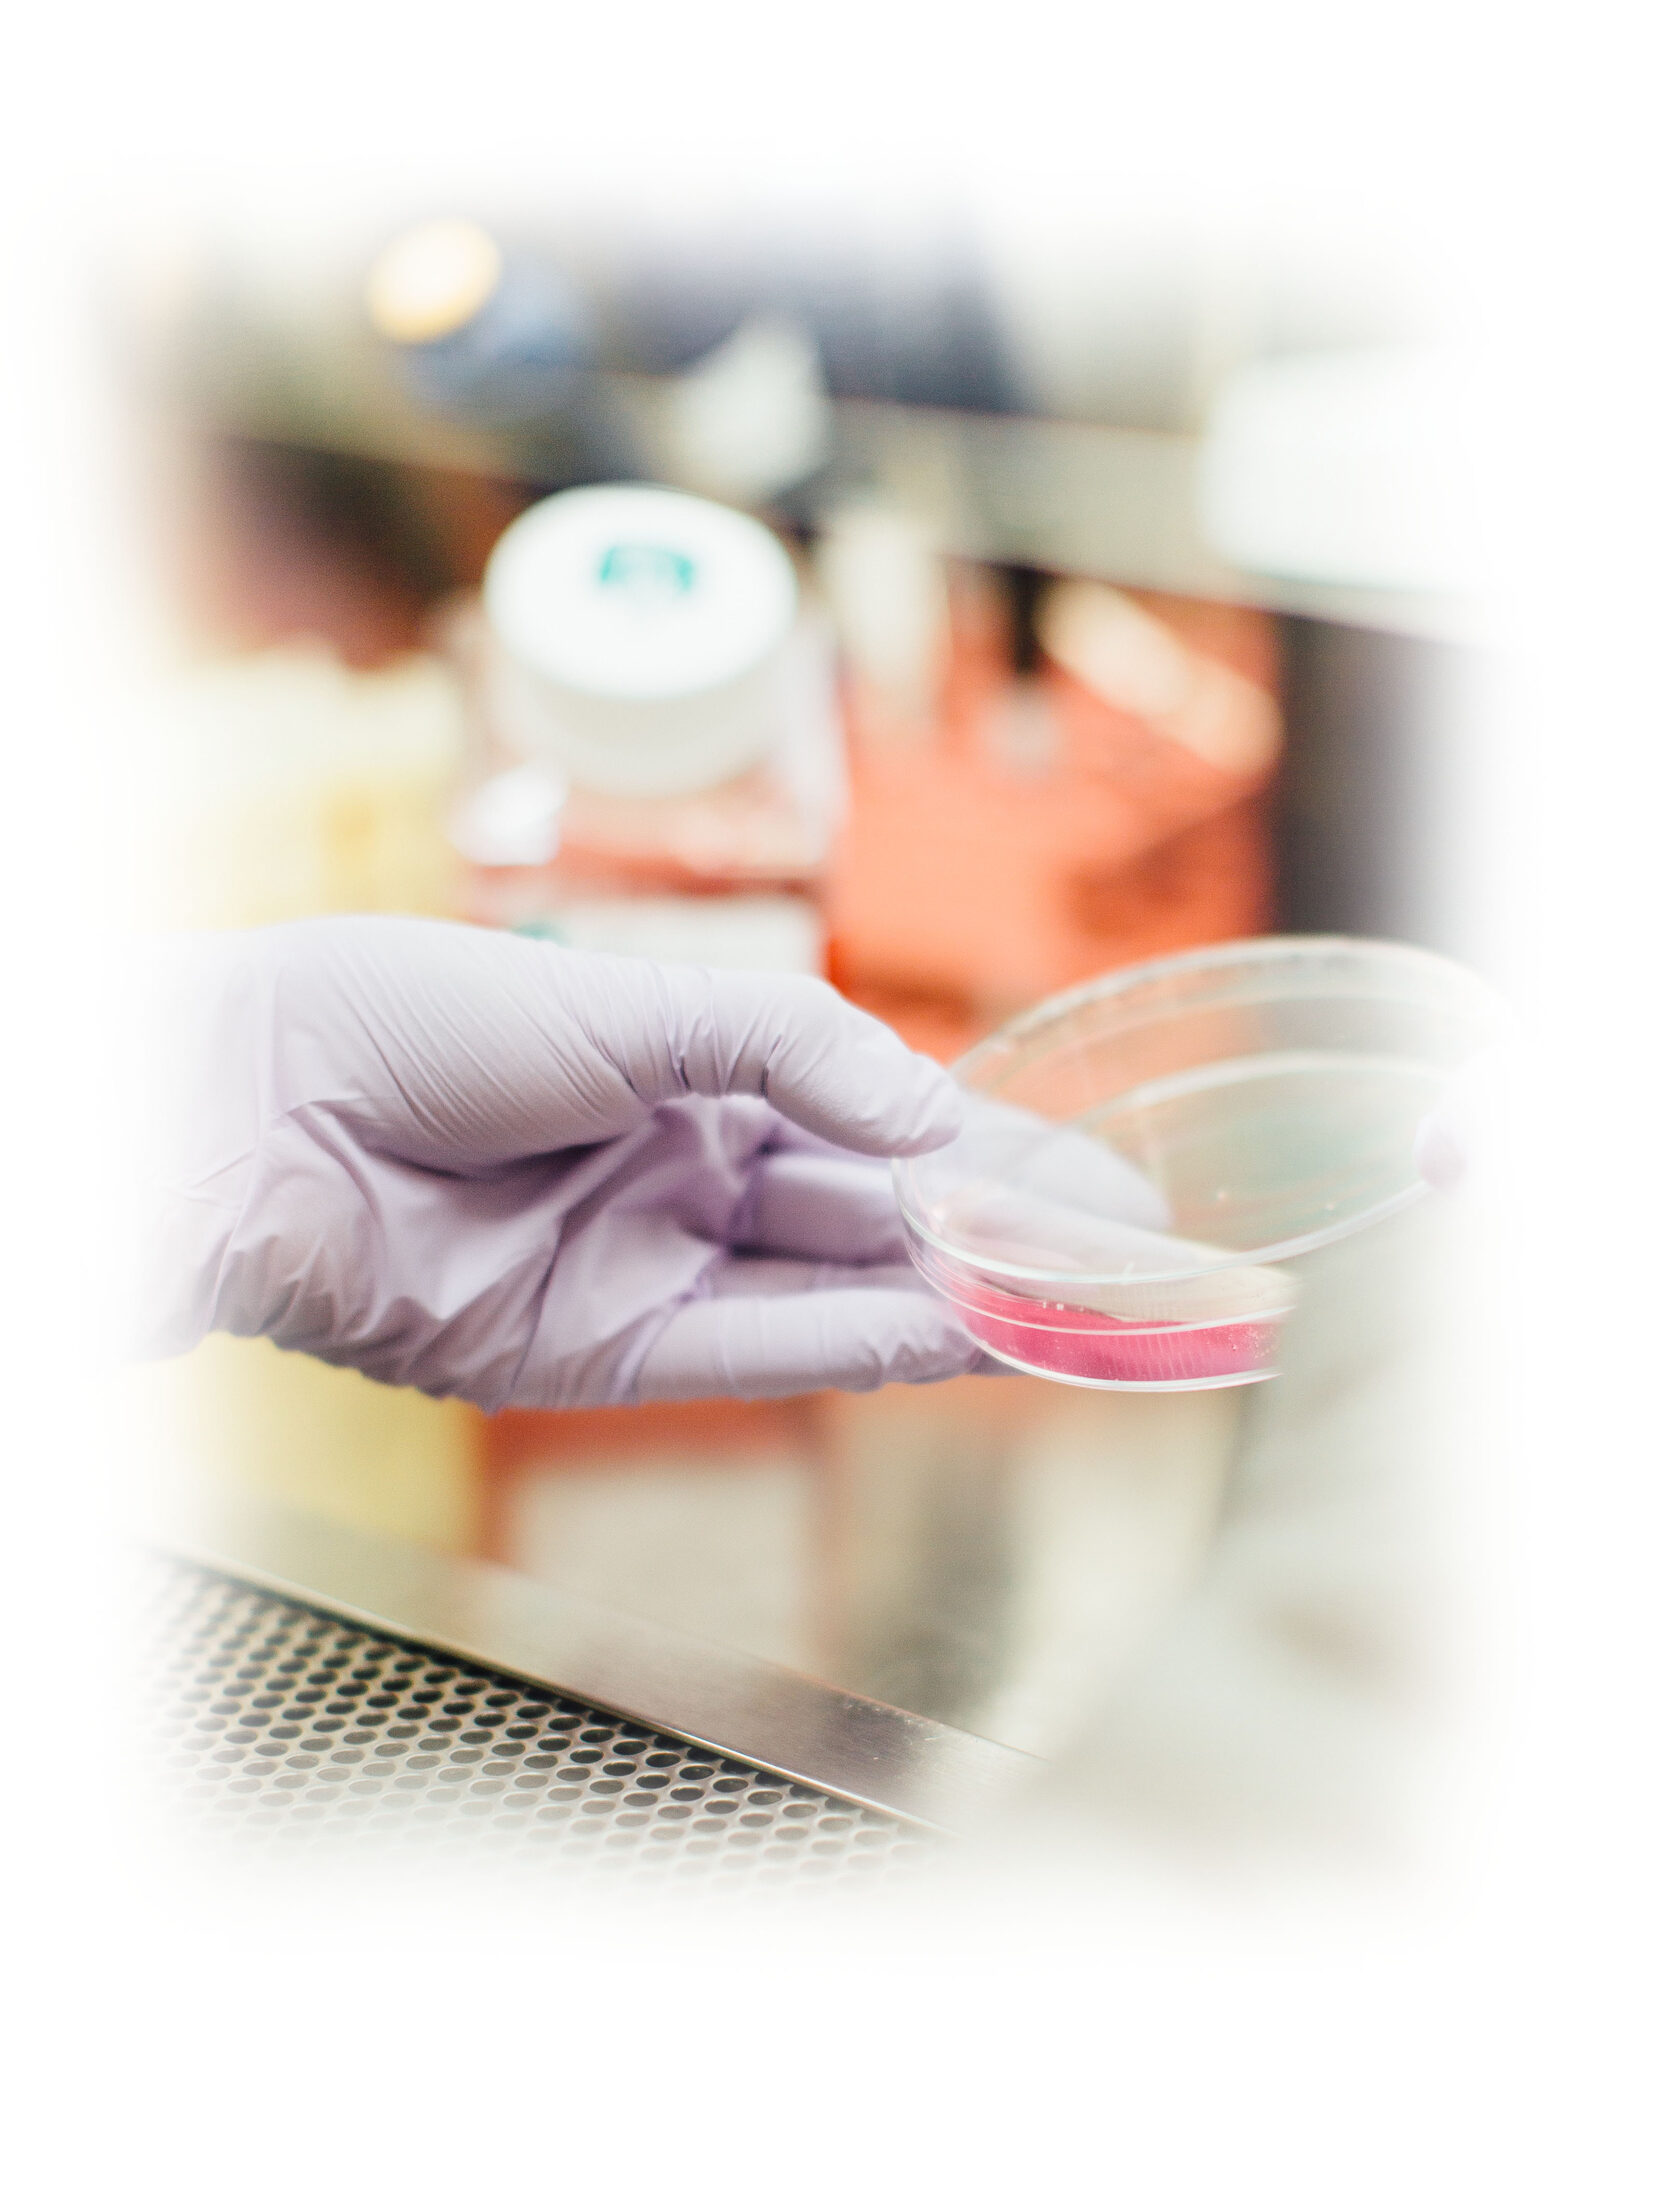

О ПРОИЗВОДСТВЕ
ПРОДУКЦИЯ
НОВОСТИ
FAQ
КОНТАКТЫ
О ПРОИЗВОДСТВЕ
ПРОДУКЦИЯ
НОВОСТИ
FAQ
КОНТАКТЫ






NE VODA
Извлекая максимум пользы из природы-
достичь здоровья и гармонии
достичь здоровья и гармонии


ПОДРОБНЕЕ
В КОРЗИНУ
ПОДРОБНЕЕ
В КОРЗИНУ
ПОДРОБНЕЕ
В КОРЗИНУ
Вода из древесины сосны
Вода из древесины осины
Вода из древесины березы
Древесный сок, получаемый из хвойных пород деревьев
Экстракт биологически активных веществ из ствола этого дерева
Березовый экстракт целая сокровищница витаминов и минералов
500 р.
500 р.
500 р.










Для укрепления иммунной системы:
Содержит витамин С и многие другие полезные вещества, которые помогают укрепить иммунную систему и защитить организм от болезней.
Для улучшения состояния кожи:
Может помочь улучшить состояние кожи благодаря своим антибактериальным свойствам и способности смягчать и увлажнять кожу.
Для улучшения пищеварения:
Содержит фитонциды, которые способствуют нормализации пищеварения и улучшению работы кишечника.
Для уменьшения воспаления:
Содержит антиоксиданты, которые помогают снизить воспаление и защитить организм от повреждения свободными радикалами.
Для очищения организма:
Обладает мочегонными свойствами, которые помогают очистить почки и мочевой пузырь от токсинов и других вредных веществ.
Для улучшения настроения:
Аромат воды может помочь снять стресс и улучшить настроение.
Наши производственные процессы основаны на передовых технологиях и современном оборудовании, что позволяет нам достичь высокого качества продукта.
Наша задача, заключается в создании продукции, которая не только соответствует самым высоким стандартам, но и является воплощением инноваций в производстве.
Процесс начинается с тщательно отобранных сырьевых материалов, подвергающихся строгому контролю качества. Затем сырье подвергается обработке с применением передовых методов и технологий.
Инженеры и технические специалисты работают в тесном сотрудничестве, чтобы оптимизировать каждый этап производства.
Наша задача, заключается в создании продукции, которая не только соответствует самым высоким стандартам, но и является воплощением инноваций в производстве.
Процесс начинается с тщательно отобранных сырьевых материалов, подвергающихся строгому контролю качества. Затем сырье подвергается обработке с применением передовых методов и технологий.
Инженеры и технические специалисты работают в тесном сотрудничестве, чтобы оптимизировать каждый этап производства.





ПОДРОБНЕЕ
Производство: инновационные технологии и высокий стандарт качества

Натуральные природные компоненты оказывают положительное влияние на здоровье человека. Они содержат в себе множество полезных веществ, таких как минералы, витамины, антиоксиданты и другие элементы, которые помогают поддерживать здоровый образ жизни и защищать организм от различных заболеваний.
Например, некоторые растения содержат активные биологические соединения, которые могут улучшить функцию сердечно-сосудистой системы, повысить иммунитет, снизить уровень холестерина в крови и привести к общему улучшению самочувствия.
Например, некоторые растения содержат активные биологические соединения, которые могут улучшить функцию сердечно-сосудистой системы, повысить иммунитет, снизить уровень холестерина в крови и привести к общему улучшению самочувствия.
Результаты исследований:
ПОДРОБНЕЕ
БУДЬТЕ В КУРСЕ НАШИХ НОВОСТЕЙ!
ПОДПИСАТЬСЯ
Контакты
+1 123 4567890
hello@loftpineapple.com
Pineapple Loft, 22 Pink Street, New York
hello@loftpineapple.com
Pineapple Loft, 22 Pink Street, New York
© All Rights Reserved. Acme Design Co.
hello@mysite.com
hello@mysite.com
